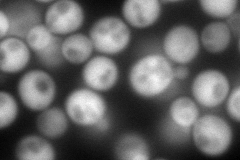
YKL024C
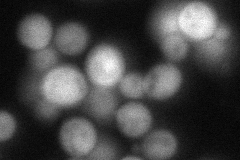
YKL024C
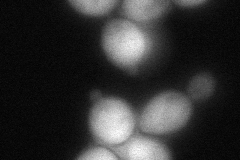
YKL024C
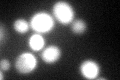
YKL024C
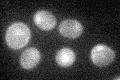
YKL024C

View description
Uridylate kinase, catalyzes the seventh enzymatic step in the de novo biosynthesis of pyrimidines, converting uridine monophosphate (UMP) into uridine-5'-diphosphate (UDP)
Localization:
Intensity:
Fold change:
Significance:
-
C’ GFP library in SD

cytosol70.17 -
N' NOP1pr-GFP in SD
cytosol,nucleus349.11 -
N' TEF2pr-mCherry in SD

ER106.54 -
N' NATIVEpr-GFP in SD
below threshold81.6967 -
N' TEF2pr-VC and Cyto-VN in SD
cytosol99.0019 -
C’ GFP library in SD+DTT
cytosol74.881.06No -
C’ GFP library in SD+H2O2

cytosol51.210.72No -
C’ GFP library in Starvation Media
cytosol31.960.45No -
C’ GFP library on the background of Pup2-DaMP

cytosol -
C’ GFP library on the background of CCT mutant

cytosol62.7170.89365No
